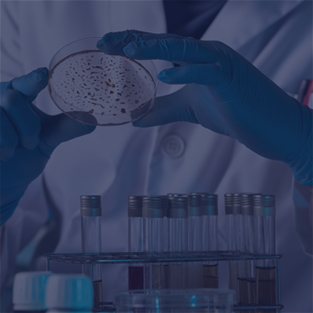
MOLECULAR-DIAGNOSIS
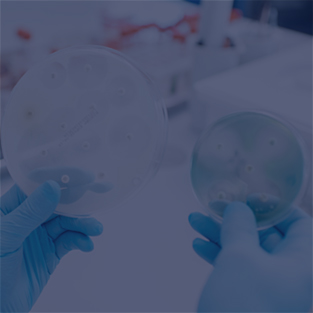
SEROLOGY

About Us
Heart for Health Pathology is staffed with highly qualified pathologists, scientists and technologists, whose knowledge and skills combine to keep Heart for Health at the forefront of South Africa's drive to excellent and reliable results.
Our Mission
Heart for Health Pathology exists to provide patient centric and value-based pathology service to support clinicians, promote health, save lives while empowering communities.
Our Vision
We intend to provide excellent, reliable, affordable, and easily accessible screening and diagnostic services to communities nationwide.
Services
Heart for Health Pathology offers 24hour pathology services in Pretoria and surrounding community of medical facilities, utilising state of the art technology on the latest instruments to provide quality results.

HAEMATOLOGY

CHEMICAL PATHOLOGY

HISTOPATHOLOGY

CYTOPATHOLOGY
MOLECULAR DIAGNOSIS

INFECTIOUS DISEASES
SEROLOGY

RESEARCH

HUMAN GENETICS

OCCUPATIONAL HEALTH & CORPORATE

MICROBIOLOGY

